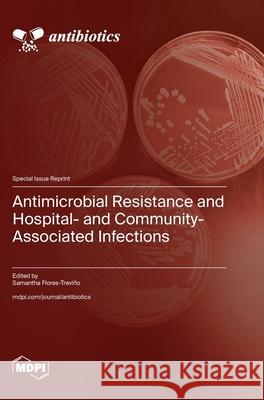
Antimicrobial Resistance and Hospital- and Community-Associated Infections

topmenu
Flores, Samantha
The Music & Arts Program for Youth, Inc. (M.A.P. for Youth) educates, empowers and enables youth to succeed by providing music, arts, character education, literacy and leadership development to create a better life for themselves, while positioning them to serve others. www.mapforyouth.com
 Rising Young Poets: A Collection of Original Poems |  Broken Hearts | Antimicrobial Resistance and Hospital- and Community-Associated Infections |










